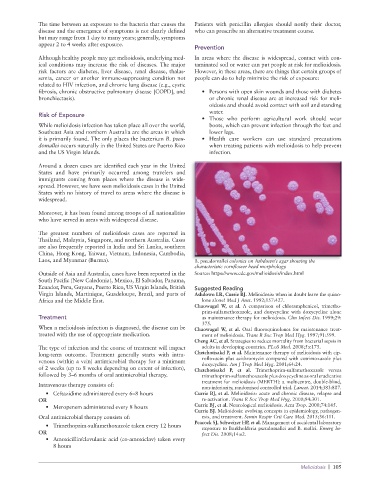

Page 107 - JSOM Winter 2021
P. 107
The time between an exposure to the bacteria that causes the Patients with penicillin allergies should notify their doctor,
disease and the emergence of symptoms is not clearly defined who can prescribe an alternative treatment course.
but may range from 1 day to many years; generally, symptoms
appear 2 to 4 weeks after exposure.
Prevention
Although healthy people may get melioidosis, underlying med- In areas where the disease is widespread, contact with con-
ical conditions may increase the risk of diseases. The major taminated soil or water can put people at risk for melioidosis.
risk factors are diabetes, liver disease, renal disease, thalas- However, in these areas, there are things that certain groups of
semia, cancer or another immune-suppressing condition not people can do to help minimize the risk of exposure:
related to HIV infection, and chronic lung disease (e.g., cystic
fibrosis, chronic obstructive pulmonary disease [COPD], and • Persons with open skin wounds and those with diabetes
bronchiectasis). or chronic renal disease are at increased risk for meli-
oidosis and should avoid contact with soil and standing
water.
Risk of Exposure
• Those who perform agricultural work should wear
While melioidosis infection has taken place all over the world, boots, which can prevent infection through the feet and
Southeast Asia and northern Australia are the areas in which lower legs.
it is primarily found. The only places the bacterium B. pseu- • Health care workers can use standard precautions
domallei occurs naturally in the United States are Puerto Rico when treating patients with melioidosis to help prevent
and the US Virgin Islands. infection.
Around a dozen cases are identified each year in the United
States and have primarily occurred among travelers and
immigrants coming from places where the disease is wide-
spread. However, we have seen melioidosis cases in the United
States with no history of travel to areas where the disease is
widespread.
Moreover, it has been found among troops of all nationalities
who have served in areas with widespread disease.
The greatest numbers of melioidosis cases are reported in
Thailand, Malaysia, Singapore, and northern Australia. Cases
are also frequently reported in India and Sri Lanka, southern
China, Hong Kong, Taiwan, Vietnam, Indonesia, Cambodia,
Laos, and Myanmar (Burma). B. pseudomallei colonies on Ashdown’s agar showing the
characteristic cornflower head morphology.
Outside of Asia and Australia, cases have been reported in the Source: https://www.cdc.gov/melioidosis/index.html
South Pacific (New Caledonia), Mexico, El Salvador, Panama,
Ecuador, Peru, Guyana, Puerto Rico, US Virgin Islands, British Suggested Reading
Virgin Islands, Martinique, Guadeloupe, Brazil, and parts of Ashdown LR, Currie BJ. Melioidosis: when in doubt leave the quino-
Africa and the Middle East. lone alone! Med J Aust. 1992;157:427.
Chaowagul W, et al. A comparison of chloramphenicol, trimetho-
prim-sulfamethoxazole, and doxycycline with doxycycline alone
Treatment as maintenance therapy for melioidosis. Clin Infect Dis. 1999;29:
375.
When a melioidosis infection is diagnosed, the disease can be Chaowagul W, et al. Oral fluoroquinolones for maintenance treat-
treated with the use of appropriate medication. ment of melioidosis. Trans R Soc Trop Med Hyg. 1997;91:599.
Cheng AC, et al. Strategies to reduce mortality from bacterial sepsis in
The type of infection and the course of treatment will impact adults in developing countries. PLoS Med. 2008;5:e175.
long-term outcome. Treatment generally starts with intra- Chetchotisakd P, et al. Maintenance therapy of melioidosis with cip-
venous (within a vein) antimicrobial therapy for a minimum rofloxacin plus azithromycin compared with cotrimoxazole plus
doxycycline. Am J Trop Med Hyg. 2001;64:24.
of 2 weeks (up to 8 weeks depending on extent of infection), Chetchotisakd P, et al. Trimethoprim-sulfamethoxazole versus
followed by 3–6 months of oral antimicrobial therapy. trimethoprim-sulfamethoxazole plus doxycycline as oral eradicative
treatment for melioidosis (MERTH): a multicentre, double-blind,
Intravenous therapy consists of: non-inferiority, randomised controlled trial. Lancet. 2014;383:807.
• Ceftazidime administered every 6–8 hours Currie BJ, et al. Melioidosis: acute and chronic disease, relapse and
OR re-activation. Trans R Soc Trop Med Hyg. 2000;94:301.
• Meropenem administered every 8 hours Currie BJ, et al. Neurological melioidosis. Acta Trop. 2000;74:145.
Currie BJ. Melioidosis: evolving concepts in epidemiology, pathogen-
Oral antimicrobial therapy consists of: esis, and treatment. Semin Respir Crit Care Med. 2015;36:111.
Peacock SJ, Schweizer HP, et al. Management of accidental laboratory
• Trimethoprim-sulfamethoxazole taken every 12 hours exposure to Burkholderia pseudomallei and B. mallei. Emerg In-
OR fect Dis. 2008;14:e2.
• Amoxicillin/clavulanic acid (co-amoxiclav) taken every
8 hours
Melioidosis | 105